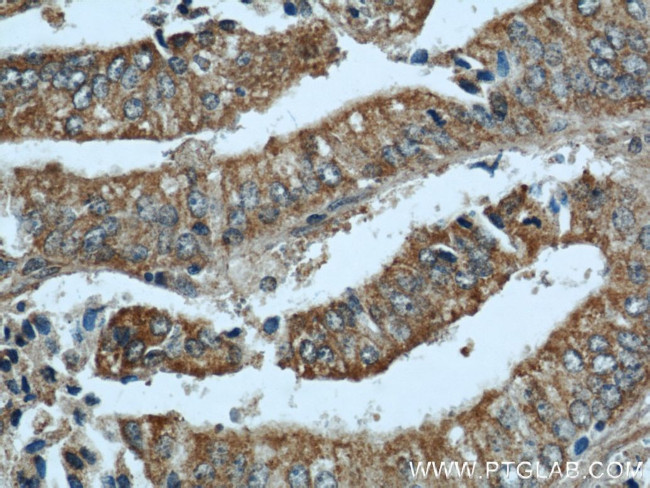
NOV Antibody in Immunohistochemistry (Paraffin) (IHC (P))

Search
Proteintech
NOV Polyclonal Antibody
{{$productOrderCtrl.translations['antibody.pdp.commerceCard.promotion.promotions']}}
{{$productOrderCtrl.translations['antibody.pdp.commerceCard.promotion.viewpromo']}}
{{$productOrderCtrl.translations['antibody.pdp.commerceCard.promotion.promocode']}}: {{promo.promoCode}} {{promo.promoTitle}} {{promo.promoDescription}}. {{$productOrderCtrl.translations['antibody.pdp.commerceCard.promotion.learnmore']}}
产品信息
55449-1-AP
宿主/亚型
分类
类型
抗原
偶联物
形式
浓度
规格
保存条件
运输条件
靶标信息
NOV is a member of the CCN family of secreted, cysteine-rich regulatory proteins. The full-length NOV protein contains four structural domains that confer distinct, and sometimes opposing, biological activities. Elevated expression of NOV is associated with certain tumors, including Wilm's tumor and most nephroblastomas. However, in other tumor types and certain cancer cell lines, increased tumorigenicity and proliferation is correlated with decreased NOV expression. Additionally, NOV induces cell adhesion and cell migration by signaling through specific cell-surface integrins, and by binding to heparin sulfate proteoglycans and to fibulin 1C. NOV has also been reported to exert proangiogenic activities.
仅用于科研。不用于诊断过程。未经明确授权不得转售。